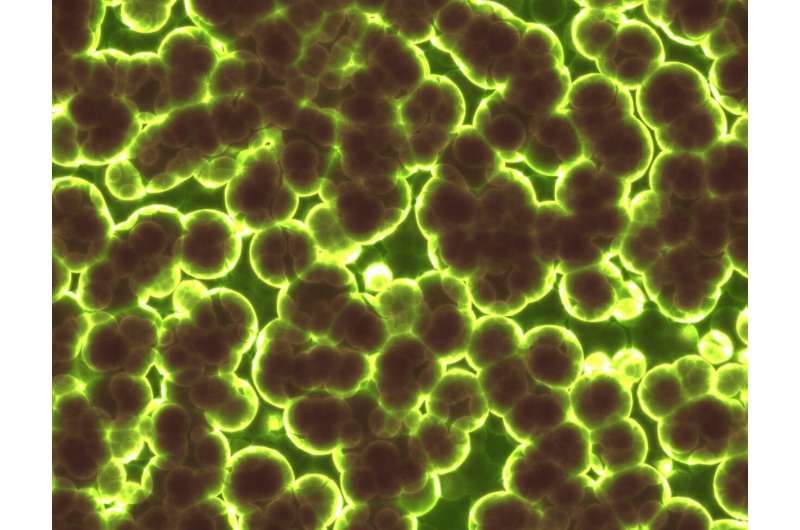
Newly discovered enzyme that turns air into electricity, providing a new clean source of energy

Newly discovered enzyme that turns air into electricity, providing a new clean source of energy
Australian scientists have discovered an enzyme that converts air into energy. The finding, published today in the journal Nature, reveals that this enzyme uses the low amounts of the hydrogen in the atmosphere to create an electrical current. This finding opens the way to create devices that literally make energy from thin air.
The research team, led by Dr. Rhys Grinter, Ph.D. student Ashleigh Kropp, and Professor Chris Greening from the Monash University Biomedicine Discovery Institute in Melbourne, Australia, produced and analyzed a hydrogen-consuming enzyme from a common soil bacterium.
Recent work by the team has shown that many bacteria use hydrogen from the atmosphere as an energy source in nutrient-poor environments. "We've known for some time that bacteria can use the trace hydrogen in the air as a source of energy to help them grow and survive, including in Antarctic soils, volcanic craters, and the deep ocean" Professor Greening said. "But we didn't know how they did this, until now."
In this Nature paper, the researchers extracted the enzyme responsible for using atmospheric hydrogen from a bacterium called Mycobacterium smegmatis. They showed that this enzyme, called Huc, turns hydrogen gas into an electrical current. Dr. Grinter notes, "Huc is extraordinarily efficient. Unlike all other known enzymes and chemical catalysts, it even consumes hydrogen below atmospheric levels—as little as 0.00005% of the air we breathe."
The researchers used several cutting-edge methods to reveal the molecular blueprint of atmospheric hydrogen oxidation. They used advanced microscopy (cryo-EM) to determine its atomic structure and electrical pathways, pushing boundaries to produce the most resolved enzyme structure reported by this method to date. They also used a technique called electrochemistry to demonstrate the purified enzyme creates electricity at minute hydrogen concentrations.
Laboratory work performed by Kropp shows that it is possible to store purified Huc for long periods. "It is astonishingly stable. It is possible to freeze the enzyme or heat it to 80 degrees Celsius, and it retains its power to generate energy," Kropp said. "This reflects that this enzyme helps bacteria to survive in the most extreme environments."
Huc is a "natural battery" that produces a sustained electrical current from air or added hydrogen. While this research is at an early stage, the discovery of Huc has considerable potential to develop small air-powered devices, for example as an alternative to solar-powered devices.
The bacteria that produce enzymes like Huc are common and can be grown in large quantities, meaning we have access to a sustainable source of the enzyme. Dr. Grinter says that a key objective for future work is to scale up Huc production. "Once we produce Huc in sufficient quantities, the sky is quite literally the limit for using it to produce clean energy."
Original article by Monash University - phys.org - 3/8/2023





